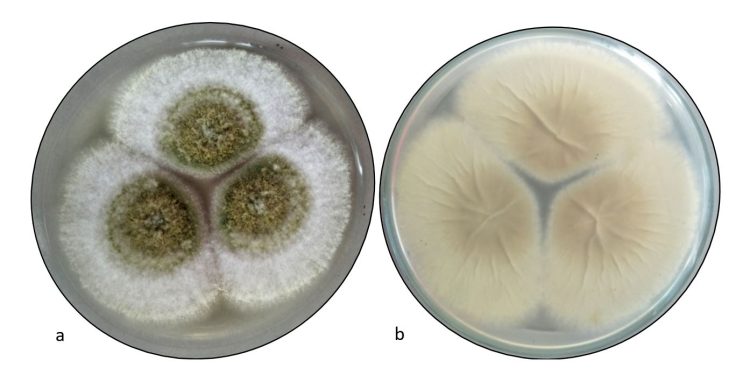
El hongo tóxico de la maldición de Tutankamón, un potente fármaco contra el cáncer

Redacción Ciencia, 29 jun (EFE).- El Aspergillus flavus es un hongo tóxico que afecta a los cultivos y que se ha relacionado con muertes en excavaciones de tumbas antiguas. Ahora, un equipo de investigadores ha convertido unas moléculas de este hongo mortal en un potente compuesto contra el cáncer.
Los investigadores, liderados por la Universidad de Pensilvania (Estados Unidos), modificaron algunas de sus moléculas y las probaron contra células leucémicas. El resultado fue un prometedor compuesto contra el cáncer que abre nuevas fronteras en el descubrimiento de más medicamentos derivados de hongos.
“Los hongos nos dieron la penicilina. Ahora estos nuevos resultados nos demuestran que aún quedan por descubrir muchos más medicamentos derivados de productos naturales”, subraya Sherry Gao, profesora de Bioingeniería en la Universidad de Pensilvania y autora principal del estudio cuyos detalles se han publicado este lunes en la revista Nature Chemical Biology.
El Aspergillus flavus, llamado así por sus esporas amarillas, ha sido durante mucho tiempo un microorganismo villano. Después de que los arqueólogos abrieran la tumba del rey Tutankamón en la década de 1920, una serie de muertes prematuras entre el equipo de excavación dio lugar a la maldición del faraón.
Décadas más tarde, los médicos teorizaron que las esporas fúngicas, latentes durante milenios, podrían haber desempeñado un papel importante.
Y en la década de 1970, una docena de científicos entraron en la tumba de Casimiro IV en Polonia, y volvió a suceder: en pocas semanas, murieron diez de ellos. Investigaciones posteriores revelaron que la tumba contenía A. flavus, cuyas toxinas pueden provocar infecciones pulmonares.
Ahora, ese mismo hongo es la inesperada fuente de una nueva y prometedora terapia contra el cáncer.
Un hallazgo poco común
La terapia en cuestión es una clase de péptidos sintetizados por ribosomas y modificados, o RiPP. El nombre hace referencia a cómo se produce el compuesto —por el ribosoma, una pequeña estructura celular que fabrica proteínas— y al hecho de que se modifica posteriormente, en este caso, para mejorar sus propiedades contra el cáncer.
Purificar estas sustancias químicas es difícil, explica Qiuyue Nie, investigadora posdoctoral en Pensilvania y primera autora del artículo.
Aunque se han identificado miles de RiPP en bacterias, solo se han encontrado unos pocos en hongos.
Para encontrar RiPP fúngicos, el equipo analizó primero una docena de cepas de Aspergillus, que según investigaciones anteriores podrían contener más de estas sustancias químicas.
Al comparar las sustancias químicas producidas por estas cepas con los componentes básicos conocidos de los RiPP, los investigadores identificaron A. flavus como un candidato prometedor para seguir estudiándolo.
El análisis genético señaló una proteína concreta de A. flavus como fuente de RiPP fúngicos. Cuando los investigadores desactivaron los genes que crean esa proteína, los marcadores químicos que indicaban la presencia de RiPP también desaparecieron.
Este novedoso enfoque, que combina información metabólica y genética, no solo identificó la fuente de RiPP fúngicos en A. flavus, sino que podría utilizarse para encontrar más RiPP fúngicos en el futuro.
— Enséñame de Ciencia (@EnsedeCiencia) June 23, 2025
Un potente medicamento
Tras purificar cuatro RiPP diferentes, los investigadores descubrieron que las moléculas compartían una estructura única de anillos entrelazados que fueron bautizadas como ‘asperigimicinas’.
Incluso sin modificaciones, cuando se mezclaron con células cancerosas humanas, las asperigimicinas demostraron su potencial médico: dos de las cuatro variantes tuvieron efectos potentes contra las células leucémicas.
Otra variante, a la que los investigadores añadieron un lípido que también se encuentra en la jalea real y que nutre a las abejas en desarrollo, funcionó tan bien como la citarabina y la daunorrubicina, dos fármacos aprobados por las autoridades sanitarias estadounidenses que durante décadas se han utilizado para tratar la leucemia.
A través de experimentos adicionales, los investigadores descubrieron que las asperigimicinas probablemente interrumpen el proceso de división celular.
Las células cancerosas se dividen de forma incontrolada. Estos compuestos bloquean la formación de microtúbulos, que son esenciales para la división celular, explica Gao.
Cabe destacar que los compuestos tuvieron poco o ningún efecto sobre las células cancerosas de mama, hígado o pulmón, ni sobre una serie de bacterias y hongos, lo que sugiere que los efectos disruptivos de las asperigimicinas son específicos de ciertos tipos de células, una característica fundamental para cualquier medicamento futuro.
Además de demostrar el potencial médico de las asperigimicinas, los investigadores identificaron grupos similares de genes en otros hongos, lo que sugiere que aún quedan por descubrir más RiPPS fúngicos.
El siguiente paso es probar las asperigimicinas en modelos animales, con la esperanza de pasar algún día a ensayos clínicos en humanos.
Puede interesarle:
OMS: Egipto es ya el primer país del mediterráneo oriental en controlar la hepatitis B
ir